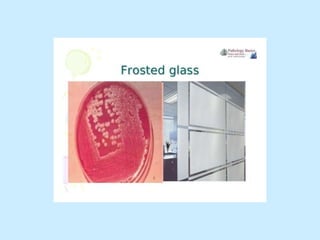

The document provides an overview of Bacillus species, particularly Bacillus anthracis and Bacillus cereus, detailing their gram-positive characteristics, pathogenicity, and the diseases they cause, such as anthrax. It describes the clinical forms of anthrax, diagnostic methods, and treatment options, emphasizing the need for early intervention with antibiotics like ciprofloxacin. Additionally, it highlights the anthrax vaccine and the implications of Bacillus anthracis as a bioterrorism agent.